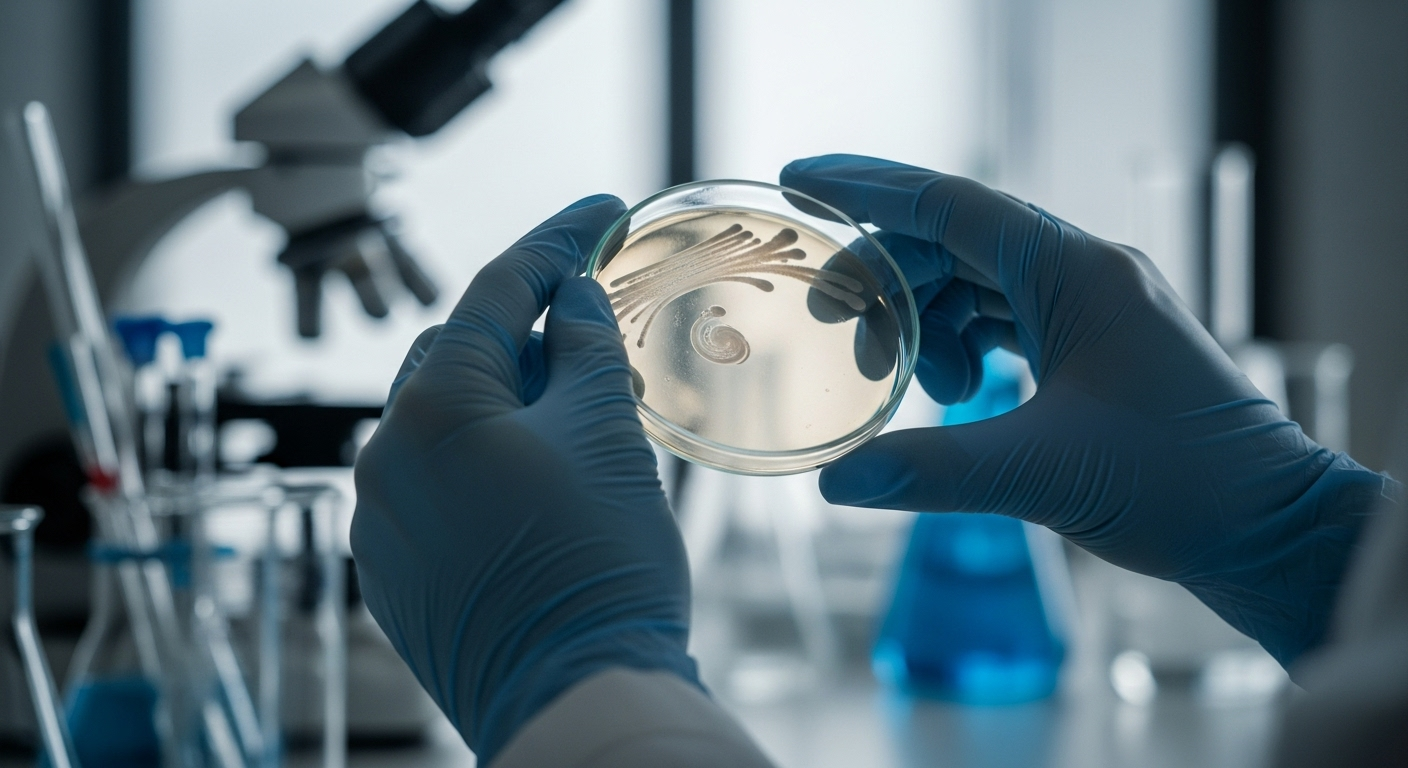
L'espoir d'un « effet boule de neige »

Solidarité dans Charlevoix : un record de 45 000 $ récolté pour soutenir la recherche et les malades atteints de la SLA
Auteur: Adam David
L’air était chargé d’une émotion particulière, ce jour-là, à La Malbaie. Secouée par de récentes révélations sur une concentration anormale de cas de sclérose latérale amyotrophique (SLA), la communauté de Charlevoix a répondu par une mobilisation sans précédent, récoltant plus de 45 000 dollars lors de sa marche annuelle. Un record qui sonne comme un cri du cœur, un mélange d’espoir et de défi face à la maladie.
L'onde de choc d'une enquête médiatique

Ce n’est pas un hasard si cette 20e édition a pris une telle ampleur. Quelques jours plus tôt, un reportage de l’émission J.E., mené par le Bureau d’enquête, mettait en lumière une situation qui inquiète depuis longtemps dans la région. Assez pour que la Santé publique soit poussée à lancer une enquête pour dresser un portrait épidémiologique précis de la SLA dans Charlevoix-Est. La marche de cette année n’était donc pas seulement une collecte de fonds ; c’était une affirmation collective.
Depuis ses débuts, l’événement a permis d’amasser plus de 300 000 dollars. Mais la somme de 45 275 $ récoltée cette fois-ci a une saveur particulière. C’est la réponse d’un territoire qui refuse de rester dans l’incertitude.
« Des gens formidables qui sont vraiment unis »

Pour Claudine Cook, directrice générale de SLA Québec, cette solidarité n’a rien d’étonnant. Elle décrit Charlevoix comme « une communauté où les habitants se connaissent tous ». C’est ce tissu social serré qui explique, selon elle, cette capacité à se mobiliser. « C’est des gens formidables qui sont vraiment unis pour se soutenir un pour les autres et pour lever des fonds pour la recherche », confie-t-elle.
Une union qui se sentait à chaque pas, dans chaque conversation. On ne marchait pas seulement pour une cause, mais pour un voisin, un ami, un membre de sa famille.
L'espoir d'un « effet boule de neige »
Elsa Tremblay, l’organisatrice de la marche, sent bien que quelque chose a changé. L’attention médiatique, bien que née d’une inquiétude, pourrait être le déclencheur tant attendu. « Ça va faire un effet boule de neige », espère-t-elle. Si l’enquête confirme qu’il y a bien plus de cas ici qu’ailleurs, alors les choses pourraient s’accélérer : « on va aller s’intéresser aux facteurs de risque, aux causes, et là ça va donner plus de visibilité. »
Une revendication concrète a d’ailleurs émergé de ce mouvement : la nécessité d’un registre officiel des patients. « Ça nous prend absolument un registre en bonne et due forme pour qu’on soit capable d’identifier qui a eu la SLA », martèle-t-elle. Sans données fiables, pas de recherche sérieuse possible.
Le visage humain de la lutte : « la vie est trop belle »

Au cœur de cette foule, il y a des visages. Celui de Martin Lavoie, lui-même atteint par la maladie, a été particulièrement remarqué. Récompensé pour son dévouement, il incarne cette résilience qui force l’admiration. « J’aime tellement la vie. Je suis tellement bien entouré. Pourquoi lâcher ? Non, la vie est trop belle à vivre », a-t-il partagé avec une émotion palpable.
Pour lui, la mobilisation actuelle n’est pas qu’un feu de paille. « Oui, ça bouge, puis ça va continuer de bouger. On ne lâchera pas le morceau », assure-t-il, convaincu que le soutien populaire est le moteur qui fera avancer la recherche. « On a le potentiel pour garder ça vivant. »
un an d'attente, une vie de solidarité

L’argent récolté servira à la fois à soutenir directement les familles touchées par la SLA et à financer la recherche. Un double objectif vital, car comme le rappelle Elsa Tremblay, « un seul essai clinique, ça coûte des millions juste pour tester une molécule ». Chaque dollar compte.
Le chemin est encore long. Les résultats de l’enquête de la Santé publique ne sont pas attendus avant au moins un an. Une attente qui pourrait être angoissante, mais que la communauté de Charlevoix semble déterminée à traverser ensemble, en se soutenant les uns les autres. Un pas après l’autre.
Selon la source : qub.ca










